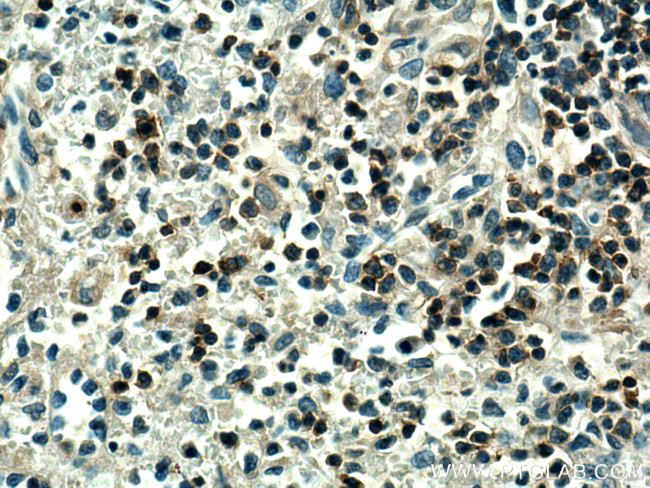
PTPRCAP Antibody in Immunohistochemistry (Paraffin) (IHC (P))

Search
Proteintech
PTPRCAP Polyclonal Antibody
{{$productOrderCtrl.translations['antibody.pdp.commerceCard.promotion.promotions']}}
{{$productOrderCtrl.translations['antibody.pdp.commerceCard.promotion.viewpromo']}}
{{$productOrderCtrl.translations['antibody.pdp.commerceCard.promotion.promocode']}}: {{promo.promoCode}} {{promo.promoTitle}} {{promo.promoDescription}}. {{$productOrderCtrl.translations['antibody.pdp.commerceCard.promotion.learnmore']}}
产品信息
28286-1-AP
种属反应
宿主/亚型
分类
类型
抗原
偶联物
形式
浓度
规格
纯化类型
保存液
内含物
保存条件
运输条件
产品详细信息
Aliquoting is unnecessary for -20°C storage.
靶标信息
MSK-1 is a mitogen and stress activated protein kinase-1 which belongs to the AGC family of kinases and is related in structure to the ribosomal p70 S6 kinase subfamily. MSK-1 can be activated by ERK1/2 and SAPK2 /p38 MAP kinase. It is also known to be required for the phosphorylation of CREB, ATF1 H3 and HMG-14 in response to mitogen and stress. Similar to RSK, MSK-1 contains two kinase domains (N-term and a C-term). Once phosphorylated on Thr581 and Ser360 by ERK1/2 and SAPK2/p38, MSK-1 autophosphorylate on at least 5 sites. Of these autophosphorylation sites Ser212 and Ser376 get phosphorylated by the C-terminal kinase domain of MSK-1 which is essential for the catalytic activity of the N-terminal kinase domain.
仅用于科研。不用于诊断过程。未经明确授权不得转售。
生物信息学
蛋白别名: CD45 associated protein; CD45-AP; CD45-associated protein; Lymphocyte phosphatase-associated phosphoprotein; Protein tyrosine phosphatase receptor type C-associated protein; protein tyrosine phosphatase, receptor type, c polypeptide-associated protein; PTPRC-associated protein; PTPRCAP; unnamed protein product
基因别名: CD45-AP; LPAP; PTPRCAP
UniProt ID: (Human) Q14761
Entrez Gene ID: (Human) 5790